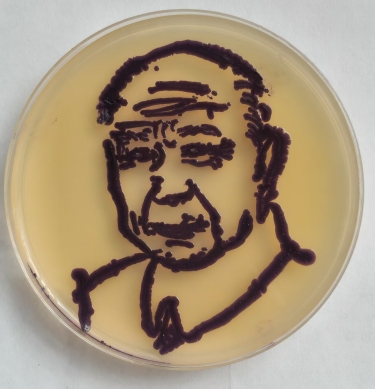

近日,由辽宁省教育厅主办的2025“君立康杯”辽宁省普通高等学校本科大学生微生物科学与艺术设计大赛圆满结束。我院参赛团队凭借扎实的专业知识、出色的艺术创意与默契的团队协作,在激烈竞争中脱颖而出,共荣获一等奖5项、二等奖3项、三等奖8项,取得了历史性的突破,展现了学院在人才培养方面的显著成效。

微生物教师团队在赛前全程悉心指导,深耕赛程各环节,为作品质量提升提供了坚实的专业支持。在科学层面,教师紧扣赛事要求,指导学生团队设计严谨可行的实验方案,确保微生物形态与结构呈现的科学性与准确性;在艺术表达上,从构图布局、色彩搭配到表现载体,团队均在教师细致建议下反复调整与优化。教师们不仅参与选题论证与方案推敲,更注重在过程中启发学生思维、传授方法,有效提升了学生的跨学科整合能力、团队协作意识与创新实践素养,助力他们在科学严谨与艺术创意之间实现有机融合,为最终取得优异成绩奠定了重要基础。




《菌绘八秩 从烽火到繁花》
2309李佳诺、陶晴 2404何佳乐2410崔馨卉




《以史为鉴·守护和平》
2409刘莹、王璐、付佳卉、常浩涵

《菌绘四贤,续国之华章》
2307王美玉、刘雯静、胡涵雨

《菌语中国》
2307许蓝心、陈佳琪2308蔡怡婧2309庞倩


《忆峥嵘岁月,绘和平锦绣》
2307郭佳钰、包帅、王亦晨
我院长期以来坚持以“学科交叉融合”为育人导向,将高水平赛事作为提升学生专业能力与创新素养的重要平台。围绕本届大赛“微生物+艺术”的鲜明特色,提前谋划、系统布局,整合微生物学、设计学等多学科师资与资源,构建起贯通“科学—艺术”的备赛支持体系。在具体实施中,不仅明确团队分工、优化备赛流程,更全力协调专业实验室、菌种资源与艺术创作空间,及时解决设备、材料等实际困难,助力学生快速理解赛事要求、掌握创作方法,为参赛团队取得优异成绩提供了坚实保障。



此次获奖,既是对我院学子专业素养与创新能力的充分认可,更是持续推动“学科交叉融合”育人模式、深化实践教学改革成果的生动体现。展望未来,我院将继续拓展优质学科竞赛与创新实践平台,支持学生在专业领域精耕细作、在交叉融合中大胆探索,不断激发科学思维与艺术创意的火花,努力培养更多具备扎实学识、创新能力和跨界素养的优秀人才,为化学与生命科学领域的发展注入新的活力!
此次获奖,既是对我院学子专业素养与创新能力的充分认可,更是我院持续推进“学科交叉融合”育人模式、深化实践教学改革的生动体现。展望未来,我院将继续拓展优质学科竞赛与创新实践平台,支持学生在专业领域精耕细作、在交叉融合中大胆探索,不断激发科学思维与艺术创意的火花,努力培养更多具备扎实学识、创新能力和跨界素养的优秀人才,为化学与生命科学的融合发展贡献新的智慧与力量!